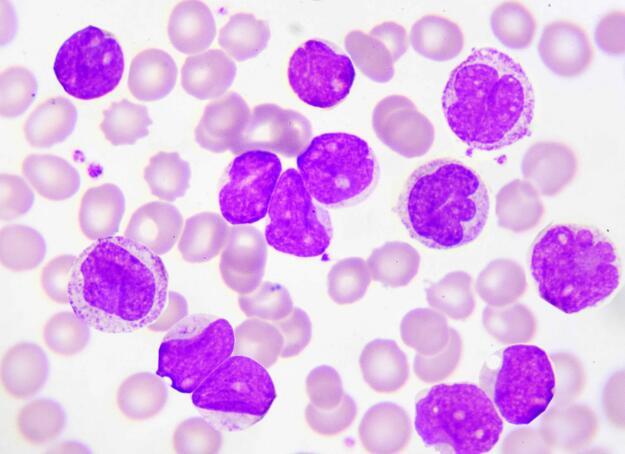

大家好,我今天想和大家聊聊一个不太为人知,但又极其重要的东西——肺细胞角蛋白。这听起来可能有点像外星语,但它其实是我们身体里的小英雄,默默守护着我们的呼吸系统。
想象一下,我们每天都在呼吸,但你知道吗?这些呼吸的背后,有一群小战士在不停地工作,它们就是肺细胞角蛋白。这些小家伙就像是编织了一张网,紧紧地包裹着我们的肺细胞,保护它们不受伤害。无论是抽烟、空气污染,还是病毒的侵袭,它们都首当其冲,用它们那坚韧的身体,为我们挡下一次又一次的攻击。

有时候,我会想,如果没有这些肺细胞角蛋白,我们的肺会变成什么样?可能就像是一座没有守卫的城池,随时都可能被敌人攻破。所以,每当我深吸一口气,我都会在心里默默地感谢这些小英雄,感谢它们无时无刻不在保护着我们。
但是,我们也不能因此就掉以轻心。肺细胞角蛋白虽然强大,但它们也需要我们的关爱和保护。


tokenpocket官网版下载:https://cjge-manuscriptcentral.com/software/65916.html